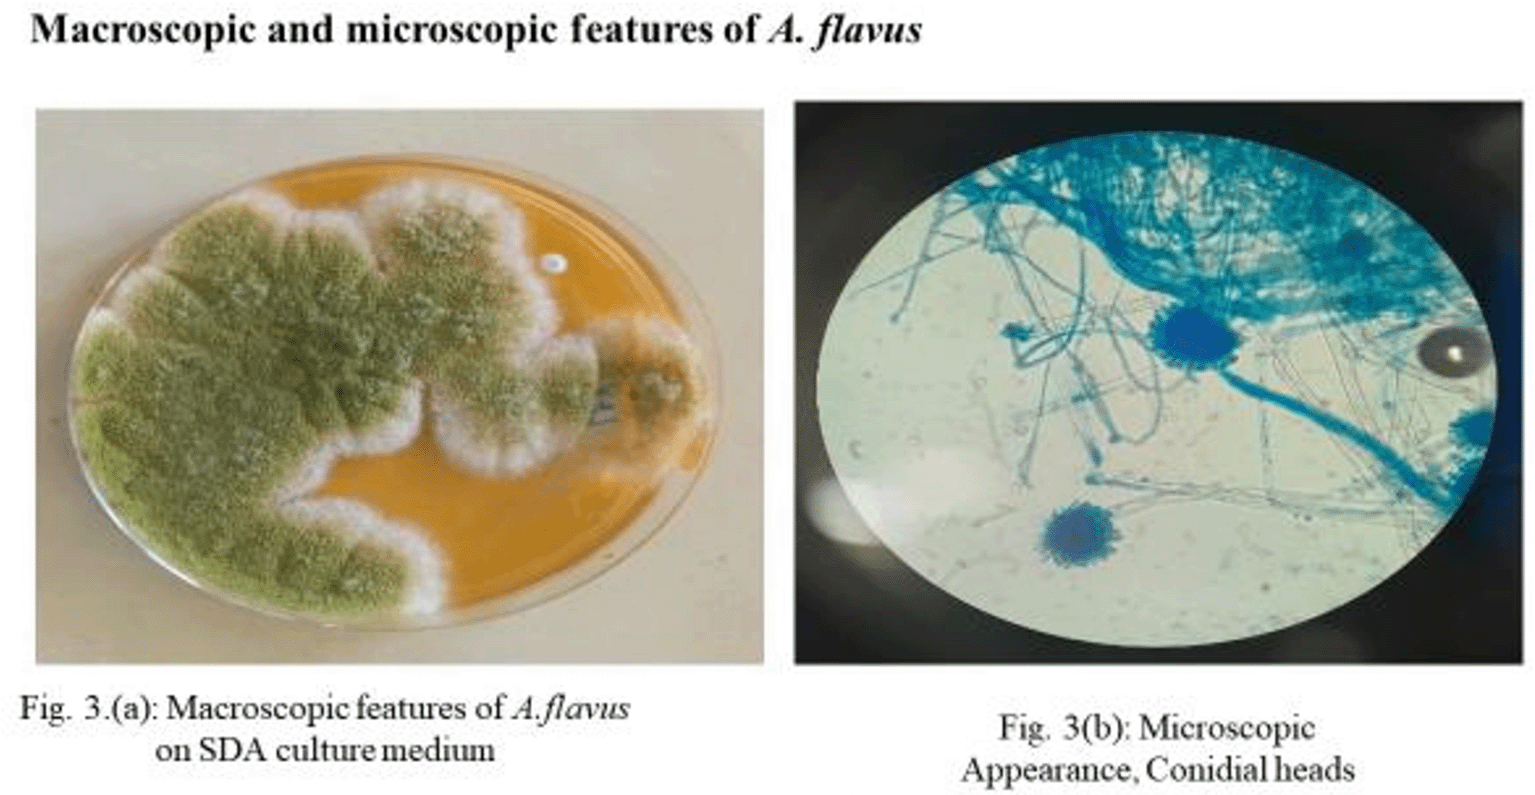

Keywords
Aspergillus spp, Histoplasma , Antifungal Resistance , Prison inmates
The emergence of antifungal resistance in fungal pathogens highlights the need for local epidemiological data to guide empirical therapy in clinical settings. Fungal research and anti-fungal drug resistance studies are limited in developing countries; hence, there is a need for burden estimation in low- and middle-income countries. This study aimed to determine the spectrum of fungal pathogens and the anti-fungal resistance profile of fungal pathogens isolated from the respiratory and urinary tracts of prison inmates in Nairobi, Kenya.
A cross-sectional study was conducted in which sputum and urine samples were obtained from inmates presenting with symptoms of respiratory and urogenital infections at a prison outpatient clinic. One hundred and sixty-two samples were collected and subjected to fungal investigation using standard protocols. Susceptibility to fluconazole, itraconazole, and voriconazole was assessed using standard broth microdilution. Clinical and sociodemographic data were obtained using a structured questionnaire.
From the 162, 94 samples were positive for fungal pathogens, with an overall prevalence of 58%. Seventeen (11%) of the isolated fungi were Aspergillus fumigatus, Aspergillus flavus and Histoplasma. There was a statistically significant difference between fungal pathogens isolated from the respiratory and urogenital tracts in both sexes (p<0.05). Antifungal susceptibility testing against itraconazole showed 2 of Aspergillus flavus and Aspergillus fumigatus were resistant. Two isolates (16.7%) one each of A.flavus and A. fumigatus, respectively , tested positive for the resistance gene cyp51a.
Mycological agents are significant causes of respiratory and UTI infections among prison inmates, which could be attributed to prison conditions and misdiagnosis as bacterial infections. This highlights the need for specific control measures to reduce exposure to fungal infections in prisons and in the general population.
Aspergillus spp, Histoplasma , Antifungal Resistance , Prison inmates
In this new version, I have added graphs to illustrate the specific objectives. I have included diagrams of both macroscopic and microscopic isolates of the Aspergillus species. Additionally, I have added a section on gel electrophoresis showing the resistant gene cyp51a.
In the discussion section, I have included information on the minimum inhibitory concentrations of the drugs and the Cyp51a gene.
To read any peer review reports and author responses for this article, follow the "read" links in the Open Peer Review table.
Human fungal infections are increasingly causing health and economic burdens at different echelons, including personal, community, national, and global levels.1–4 Despite growing concerns, fungal infections receive very little attention and resources, leading to a scarcity of quality data on fungal disease distribution and antifungal resistance patterns. Similarly, the exact burden of fungal diseases and antifungal resistance is limited; therefore, the response is undermined.5 Arising from this health concern, 19 fungal pathogens are grouped into three priority categories: critical, high-risk, and medium. The criteria for categorization are based on the average case fatality, number of new cases annually, complications and sequelae, and antifungal resistance. Among the species in the critical group and high category were Cryptococcus neoformans, Aspergllus fumigatus and Candida albicans in the critical group, and Histoplasma spp., Fusarium spp., and Candida glabrata in the high group species.5
Studies on the prevalence of fungal diseases affecting the pulmonary and urogenital systems of inmates in Kenyan prisons have rarely been documented. However, the prevalence of other infections has also been widely reported. Studies on the prevalence of respiratory diseases caused by fungal pathogens in Kenya’s prison system remain limited. Besides a study at Kamiti Maximum Prison on the prevalence of active pulmonary TB and another on modifiable factors associated with pulmonary TB in inmates from Nakuru Maximum prisons no study has been undertaken on fungal pathogens afflicting inmates in prisons.6,7
Histoplasma capsulatum and Cryptococcocus neoformans can cause pulmonary and urogenital infections.8,9 The two pathogens have not been elucidated in the two prisons, despite their unique and paradoxically neglected yet highly pathogenic nature. Histoplasma species are not endemic to tropical regions, such as Kenya. The prison microenvironment offers favorable conditions for the proliferation of fungal pathogens missed during routine microbiological diagnosis. Misdiagnosis and inappropriate prescription practices not only prolong illness, but also drive antimicrobial resistance. Furthermore, the management of fungal infections is still highly constrained by the narrow spectrum of antifungal classes of antifungal drugs and the pharmacological toxicity associated with some of these drugs.10 It is necessary to establish the spectrum and antifungal susceptibility of respiratory and urogenital fungal pathogens among prison inmates.
Urinary tract infections have been studied extensively in diverse communities and among different age groups, but they have not been fully explored in prison inmates, whose health is often neglected.1 Transmission of respiratory and urogenital infections is enhanced in crowded environments, such as schools, offices, hospitals, and prisons. Prisons worldwide often experience overcrowding, and Kenya is no exception. This situation, coupled with other factors such as delayed diagnosis, often makes prisons a prime area for the spread of respiratory and urogenital infections among inmates.11 The prison population has a high prevalence of serious, often life-threatening, infections. When prisoners are released back into the community, they carry back new and untreated infectious diseases that pose a threat to community health and add to the burden of disease in the community. Thus, there is compelling interest in society that this vulnerable group receives health protection and treatment for any ill health.12
Resistance to currently available antifungal agents can develop via acquired mechanisms following exposure to antifungal drugs. The findings of this study highlight the significance of fungal infections in prison that will guide relevant institutions in planning and policy development in such confined settings.
The study was conducted at a male maximum and female prison institution in Nairobi County. The Maximum prison has a capacity of 1400 prisoners but now houses 1800 and 2500 prisoners. Women’s prison is the largest in Kenya, with a capacity of 700 inmates. The two maximum prisons were selected purposely as the research site because of their geographical location, capacity, and proximity to the prison headquarters, allowing access to records as well as some key informants to participate in the study.
This was a cross-sectional study with laboratory investigation. Through purposive sampling, inmates with clinical symptoms of respiratory tract infections and UTI were recruited between January 2023 and March 2023. Sputum and urine samples were collected and shipped to the Mycology Division, Centre for Microbiology Research, Kenya Medical Research Institute (KEMRI) for fungal investigations using standard protocols. The isolates were identified using macro-and microscopic features. Antifungal susceptibility was determined using the broth microdilution method. Sociodemographic information, diagnosis, and intervention were sought using the data collection tool from consenting prison inmates. The study population consisted of adolescent and adult men and women aged 18-76 years old who were crime suspects or convicts at the prison and presented with clinical manifestations of respiratory and urogenital infections.
Fungal culture and identification
Sputum and urine samples were subjected to direct microscopy and cultured on Sabouraud dextrose agar supplemented with chloramphenicol (16 mg/ml). The inoculated SDA plates were incubated at 35°C for four weeks and examined daily for growth. Yeast isolates were differentiated using the CHROMagar® Candida and Dalmau techniques. Morphological features, such as hyphae, pseudohyphae, blastospores, chlamydospores, basidiospores, and sporangia, were noted.
Mold identification was performed using standard macroscopic features, such as colony growth rate, surface color, and reverse, texture, and diffusing pigments. Microscopic features of lactophenol cotton blue stain at ×40 magnification such as conidia, shape, and arrangement of phialides, were used. Clarus Histoplasma GM Enzyme Immunoassay (IMMY, Norman Oklahoma) was used to detect Histoplasma antigens in urine samples according to the manufacturer’s instructions.13 Titres of 1.0 EIA units were interpreted as positive for histoplasma antigen, whereas values less than 1.0 were interpreted as negative.
Antifungal resistance testing
The minimum inhibitory concentrations of fluconazole, itraconazole, and voriconazole were determined using the broth microdilution method.14 Briefly, 9.6 mg of azoles (Fluconazole, Itraconazole and Voriconazole) was dissolved in 3.0 ml of DMSO to get 1600 μg/ml (Sigma chemicals, USA) stock drug concentration while the required concentration was achieved with further dilution with RPMI. Briefly, the final dilution was achieved by serial dilution where 4.9 ml of RPMI was added to each of the ten tubes. Two hundred microlitres of the test concentration was dispensed into microtiter plates and inoculated with 10 μl of the 0.2 MacFarland concentration of inoculum. The plates were then incubated at 30°C for 72 h. The MIC values of all the drugs were determined visually as the lowest concentrations with no visible growth. The European Committee on Antimicrobial Susceptibility (EUCAST) drug-susceptible control strain ATCC 46645 was used for QC. Antifungal susceptibility was interpreted based on the European Committee on Antimicrobial Susceptibility Testing (EUCAST). The results were interpreted based on the EUCAST breakpoints for itraconazole (resistant isolates: MIC > 1 mg/L) and voriconazole (resistant isolates: MIC > 2 mg/L). Eucast has no set break points for fluconazole; therefore, in this study, susceptibility testing to fluconazole was based on the Clinical and Laboratory Standard Institute M38-A2 protocol.15
DNA extraction from fungal isolates
Extraction of DNA from the fungal isolates was undertaken according to the method described by (Kumar, 2018). Mycelial tufts were boiled for 10 min, vortexed and boiled for other 10 min and then centrifuged at 14,900 g for 5 min at 25 °C. 250 μl of supernatant were added to an equal amount of isopropanol, and incubated at −80°C for 30 min. After centrifugation at 14,900 g for 2 min, the pellet was washed with 70% ethanol, centrifuged at 14,900 g for 5 min, dried, and suspended in 20 μl of ultrapure H2O.
Molecular determination of antifungal resistance genes
PCR amplification of resistant genes from fungal isolates was carried according to the method described by Raja et al. (2017). Briefly, a reaction volume of 25 ul was constituted comprising of: 12.5 ul 1x Taq standard buffer [20 mM Tris/HCL (Ph 8.9@25°C), 22 mMKCl, 1.8 mM MgCl2, 22 Mm NH4Cl,0.2 mM DNTPs, 5% glycerol, 0.06% IGEPALR CA-630, 0.05% TweenR 20, 25 units/ml One Taq DNA Polymerase], template DNA 1 ul, 10 Um forward primer 0.5 ul, 10 uM reverse primer 0.5 ul and nuclease free water to 25 ul. The thermocycler PCR conditions was set as per the requirement of specific primers. For the detection of antimicrobial resistant genes, the Thermo-cycler conditions was set as initial denaturation at 95°C for 3 minutes, followed by 40 cycles of denaturation at 95°C for 1 minute, annealing at 60°C for 30 seconds, and elongation at 72°C for 1 minute 30 seconds, followed by a final elongation step at 72°C for 10 minutes in a thermal cycler.
Bases sequence of PCR primers for gene CYP51A
F - GCGCGCATGAGGGAGAT, 25 nmol 1
R - CAATGCATGAGGTTCCAGATC A, 25 nmol19
Gel electrophoresis
PCR products were run on a gel to determine resistance genes. Electrophoresis was performed in 1.5% agarose (wt/vol) in Tris-borate EDTA (TBE) buffer. A 1000 base pair (bp) DNA ladder was run concurrently with amplicons for sizing of the bands. The gel was run at 100V for 40 mins. The gel was visualized using ethidium bromide under UV illumination and photographed.
Data were analyzed using SPSS software version 26. Chi-square test and multivariate logistic regression analysis were performed to investigate the correlation between the independent variables and the isolation of fungal isolates. Chi-square test analysis was applied to determine sociodemographic factors and variables associated with fungal infections in patients with respiratory and urogenital-like symptoms. Logistic regression was used to calculate the odds ratios (ORs) with 95% confidence. Statistical significance was set at p<0.05.
The study’s Ethical approval was obtained from Institutional Ethics and Review Committee at Jomo Kenyatta University of Agriculture and Technology (Ref No: JKU/ISERC/02316/0735, 22nd September 2022), National Commission for Science Tech & Innovation (Ref No: 659559, 19th October 2022), Kenyatta National Hospital University of Nairobi Ethical Review Committee (Ref No: KNH-ERC/RR/14, 9th February 2023) and Kenya Prison Service (PRIS19/26 VOLII/167, 3rd October 2022).
Of 162 samples investigated from the two prisons, 86 were sputa and 76 were urine samples. A total of 94 (58%) samples were positive for fungi, 19 (20%) for molds, and 75 (80%) for yeasts ( Table 1). Of the 94 positive fungi, 7 (7.4%) tested positive for Aspergillus flavus and 5 (5.3%) were Aspergillus fumigatus. Histoplasma antibodies were detected in 5.3% of the samples. Aspergillus flavus was the predominant filamentous fungus isolated, as shown in Figure 1.
| Variable | Number examined N=162 | Positive fungal isolates N=94 | p value | ||
|---|---|---|---|---|---|
| Mould | Yeast | ||||
| Gender | Male | 94 | 12(13%) | 46(50%) | 1.00 |
| Female | 68 | 7(7%) | 75(79%) | ||
| Sample | Sputum | 86 | 19(20%) | 41(44%) | <0.001 |
| Urine | 76 | 0 | 34(36%) | ||
A total of 162 samples analyzed comprising 86 sputum and 76 urine samples.
Overall, 11% (17/162) of fungi (Aspergillus fumigatus, Histoplasma, Aspergillus flavus) were isolated in both facilities. However, non of the inmates tested positive for respiratory Cryptococcol infections, only 6% (10/162) of isolated fungi were from males Prisons whereby Aspergillus flavus accounted for, 4.3%, Aspergillus fumigatus accounted for 3.2% and histoplasma accounted for 3.2% 4% (7/162) of isolated fungi were from female prison whereby Aspergillus flavus accounted for 4.4%, Aspergillus fumigatus accounted for 2.9% and histoplasma accounted for 1.8%.

(a) Macroscopic features of A. flavus on SDA culture medium. (b) Microscopic appearance, conidial heads.
A total of 162 clinical samples were analyzed, comprising 86 sputum and 76 urine specimens. Among the 94 samples obtained from male inmates (sputum = 53; urine = 41), 12 (23%) respiratory samples were positive for moulds, while 27 (51%) yielded yeasts. Urogenital yeast infections were detected in 46% of urine samples from male inmates. Similarly, among the 68 samples collected from female inmates (sputum = 33; urine = 35), 7 (21%) respiratory samples were positive for moulds, and 14 (42%) were positive for yeasts. 15 (43%) of the urine sample tested positive for yeasts. Chi-square analysis revealed a statistically significant difference (p < 0.05) in the distribution of fungal isolates between the respiratory and urogenital tracts across both genders. However, no statistically significant difference (p > 0.05) was observed in the overall prevalence of fungal infections between male and female inmates.
Twelve isolates of Aspergillus fumigatus (5) and Aspergillus flavus (7) obtained from sputum samples were subjected to antifungal susceptibility testing comprising itraconazole and voriconazole. A total of 5 isolates (41.7%) were resistant to itraconazole. Only three (25 %) Aspergillus flavus isolates were resistant to itraconazole. Two (16.7 %) isolates of Aspergillus fumigatus were resistant to itraconazole. However, all Aspergillus fumigatus and Aspergillus flavus isolates were susceptible to voriconazole ( Table 2).

According to Eucast 5 strains of Aspergilus species had MIC ≥1mg/to Itraconazole. A. flavus was resistant to itraconazole at 2 mg with 25%(3/12), while Aspergillus fumigatus was resistant to Itraconazole at 4 mg/L with 16.7%(2/12).
All the 12 Aspergillus species were sensitive to voriconazole having MIC ≤0.5 Mg/L to voriconazole while 7(58%) of the aspergillus were sensitive to itraconazole having MIC ≤ 0.5 Mg/L.
The sensitivity rate of Aspergillus species to voriconazole was 100% and that to itraconazole was 58% ( Table 2).
Six isolates of Aspergillus fumigatus (3) and Aspergillus flavus (3) obtained from sputum samples were subjected to molecular analysis for the presence of the antifungal resistance gene, cyp51a, responsible for resistance against azole class of antifungals. However, only 2 isolates (16.7%), one each of A. flavus and A. fumigatus, respectively, tested positive for the resistance gene, while 10 other isolates tested negative.

M: Ladder100bp; Lane 1, 2 & 3: A. fumigatus clinical isolates; Lane 4, 5 & 6: A. flavus clinical isolates; Lane 3 & 4 = Isolates of A. fumigatus & A. flavus, respectively showing positive bands at 222bp for cyp51a gene.
This study demonstrated that the major etiological agents responsible for pulmonary aspergillosis were Aspergillus flavus and A. fumigatus. Among the two targeted species, A. flavus has been regarded as the most invasive Aspergillus species due to its high frequency of clinical manifestations, including cough, chest pain, fever, and dyspnea.16
All these symptoms were observed among the prison inmates enrolled in this study. The prevalence of isolated pulmonary fungal pathogens in the two prisons was 11%, which is considerably higher than that reported in the general population (0.2%) as documented by Ratemo et al. (2023). This finding provides important insight into the burden of pulmonary fungal infections in Kenya, particularly in high-risk settings such as prisons. These results are in agreement with a previous study conducted in Nigeria, which established that prison inmates with recurrent respiratory infections are more susceptible to fungal infections (Lillian et al., 2022). However, in contrast to the current study, where A. flavus was more prevalent than A. fumigatus, the Nigerian study reported A. fumigatus as the predominant etiological agent of aspergillosis, followed by A. niger and A. versicolor.18 The detection of previously undiagnosed fungal etiological agents, including A. fumigatus and Histoplasma spp., illustrates the vulnerability of incarcerated individuals to mycoses in addition to the widely documented bacterial infections, particularly tuberculosis, within the Kenyan prison system (Okaru et al., 2005). Histoplasma is a dimorphic fungus capable of transforming into a unicellular yeast form in host tissues (Ngei et al., 2020). Conversely, the absence of pulmonary cryptococcal infections among all inmates tested suggests that the participants were not significantly immunocompromised during the study period, since individuals with compromised immune systems are usually prone to systemic fungal infections, including disseminated pulmonary cryptococcosis. A significant difference was established regarding the variation of fungal infections according to anatomical sites, with respiratory tract infections being comparatively higher than urogenital tract infections. This observation could be attributed to overcrowding and poor hygienic conditions—an unfortunate but common characteristic of prison environments—which have been shown in previous studies to increase the risk of airborne fungal infections.19 No statistically significant difference in the prevalence of pulmonary fungal infections was. Antifungal susceptibility testing revealed that voriconazole was highly effective against both A. flavus and A. fumigatus, suggesting that it may be the preferred treatment for pulmonary aspergillosis caused by these species, compared with itraconazole. This observation was supported by minimum inhibitory concentration (MIC) tests, which showed that voriconazole exhibited comparatively lower MIC values than itraconazole. Similar findings have been reported by Sani et al. (2020) and Moglad et al. (2022),19 who found voriconazole and itraconazole to have the lowest MICs against Aspergillus species compared to other antifungal agents. In this study, voriconazole demonstrated ideal in vitro potency against Aspergillus species, and no resistant isolates were detected.20
However, the observation that isolates of both A. flavus and A. fumigatus tested positive for the antifungal drug resistance gene cyp51A presents a serious challenge in the management of respiratory aspergillosis. Resistance to azole antifungals among Aspergillus species has been associated with mutations in the cyp51A gene, which encodes the target enzyme for azole drugs, thereby contributing to therapeutic failures (Xu et al., 2024). The emergence of azole-resistant Aspergillus strains poses significant limitations to effective therapy and could result in elevated morbidity and mortality rates among highly vulnerable populations, including those in incarceration.
This study established that Aspergillus flavus and A. fumigatus are the major etiological agents responsible for pulmonary aspergillosis among the prison inmates. The detection of these fungal pathogens highlights the substantial risk of both pulmonary and urogenital fungal infections in correctional facilities, likely exacerbated by overcrowding and poor hygiene conditions. In addition, this study highlights the presence of Histoplasma and other fungal infections associated with respiratory and urogenital infections in prison settings in Kenya, underscoring the vulnerability of incarcerated populations to a broad spectrum of mycotic diseases. The findings further revealed that A. flavus and A. fumigatus isolates exhibited higher susceptibility to voriconazole than to itraconazole, suggesting that voriconazole may serve as the preferred antifungal agent for treating aspergillosis in these settings. Continuous surveillance of fungal infections, coupled with improved infection control measures and regular screening in prisons, is therefore recommended to mitigate the burden of fungal diseases among incarcerated populations.
The study’s Ethical approval was obtained from Institutional Ethics and Review Committee at Jomo Kenyatta University of Agriculture and Technology (Ref No: JKU/ISERC/02316/0735, 22nd September 2022),National Commission for Science Tech & Innovation (Ref No: 659559, 19th October 2022) Kenyatta National Hospital University of Nairobi Ethical Review Committee (Ref No: KNH-ERC/RR/14, 9th February 2023) and Kenya Prison Service (PRIS19/26 VOLII/167, 3rd October 2022).
Written informed consent for the participation of participants was obtained from the participants.
Spectrum and Antifungal drug resistance of fungal pathogens, https://doi.org/10.6084/m9.figshare.26964148.v1.22
Data citation: Jackson, Larry; Njerawana, Sally; Chebon, Samson; Bii, Christine (2024). Data set: Spectrum and antifungal drug resistance of fungal pathogens. figshare. Dataset. https://doi.org/10.6084/m9.figshare.26964148.v1.
This project contains the following underlying data:
- Raw Data of samples
- Minimum Inhibitory concentrations of the antifungal
- Histoplasma antigen results
Data are available under the terms of the Creative Commons Attribution 4.0 International license (CC-BY 4.0).
Figshare: Extended Data, https://doi.org/10.6084/m9.figshare.27037570.v1.23
Data citation: Jackson, Larry; Njerawana, Sally; Chebon, Samson; Bii, Christine (2024). Extended Data:Consent form for inmates 3.docx. figshare. Dataset. https://doi.org/10.6084/m9.figshare.27037570.v1
This project contains the following extended data
Data are available under the terms of the Creative Commons Attribution 4.0 International license (CC-BY 4.0).
Figshare: STROBE checklist of spectrum and antifungal drug resistance among fungal pathogens isolated from prison inmates in Nairobi, Kenya, https://doi.org/10.6084/m9.figshare.27038287.v1.24
Data Citation: Jackson, Larry; Njerawana, Sally; Chebon, Samson; Bii, Christine (2024). Strobe check list. figshare. Dataset. https://doi.org/10.6084/m9.figshare.27038287.v1.
| Views | Downloads | |
|---|---|---|
| F1000Research | - | - |
|
PubMed Central
Data from PMC are received and updated monthly.
|
- | - |
Is the work clearly and accurately presented and does it cite the current literature?
No
Is the study design appropriate and is the work technically sound?
No
Are sufficient details of methods and analysis provided to allow replication by others?
Partly
If applicable, is the statistical analysis and its interpretation appropriate?
Partly
Are all the source data underlying the results available to ensure full reproducibility?
Partly
Are the conclusions drawn adequately supported by the results?
Partly
Competing Interests: No competing interests were disclosed.
Reviewer Expertise: Mycology
Alongside their report, reviewers assign a status to the article:
| Invited Reviewers | |
|---|---|
| 1 | |
|
Version 2 (revision) 31 Dec 25 |
|
|
Version 1 30 Oct 24 |
read |
Provide sufficient details of any financial or non-financial competing interests to enable users to assess whether your comments might lead a reasonable person to question your impartiality. Consider the following examples, but note that this is not an exhaustive list:
Sign up for content alerts and receive a weekly or monthly email with all newly published articles
Already registered? Sign in
The email address should be the one you originally registered with F1000.
You registered with F1000 via Google, so we cannot reset your password.
To sign in, please click here.
If you still need help with your Google account password, please click here.
You registered with F1000 via Facebook, so we cannot reset your password.
To sign in, please click here.
If you still need help with your Facebook account password, please click here.
If your email address is registered with us, we will email you instructions to reset your password.
If you think you should have received this email but it has not arrived, please check your spam filters and/or contact for further assistance.
Comments on this article Comments (0)